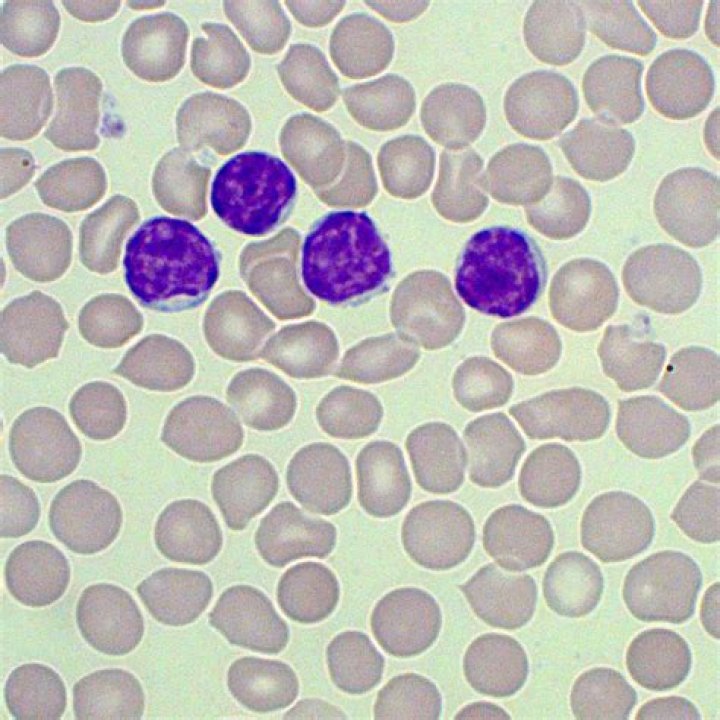
Cover

Lymphocytes can look like monocytes, except that lymphocytes do not have a kidney-bean shaped shaped nucleus, and lymphocytes are usually smaller. They have a small spherical nucleus and has abundant dark staining condensed chromatin. Not much cytoplasm can be seen, and it is basophilic (pale blue/purple staining).Similarly one may ask, what does a lymphocyte do?
Lymphocytes are white cells that are crucial to our immune systems. There are three main types known as T cells, B cells, and natural killer cells. Lymphocytes are part of our immune defense and act to recognize antigens, produce antibodies, and destroy cells that could cause damage.
Likewise, what is the normal range of lymphocytes in blood? Normal ranges and levels The normal lymphocyte range in adults is between 1,000 and 4,800 lymphocytes in 1 microliter (µL) of blood. In children, the normal range is between 3,000 and 9,500 lymphocytes in 1 µL of blood. Unusually high or low lymphocyte counts can be a sign of disease.
Simply so, what does a lymphocyte look like under a microscope?
When viewed under the microscope, lymphocytes will appear dark purple with a deep bluish nucleus and a sky blue cytoplasm.
What do eosinophils look like?
Eosinophils are specialized immune cells This proinflammatory white blood cell generally has a nucleus with two lobes (bilobed) and cytoplasm filled with approximately 200 large granules containing enzymes and proteins with different (known and unknown) functions. The eosin stains proteins (pink).
In which organ of the human body are the lymphocyte?
Human lymphoid organs. Lymphocytes develop in the thymus and bone marrow (yellow), which are therefore called central (or primary) lymphoid organs.What is a good lymphocyte level?
Normal ranges and levels The normal lymphocyte range in adults is between 1,000 and 4,800 lymphocytes in 1 microliter (µL) of blood. In children, the normal range is between 3,000 and 9,500 lymphocytes in 1 µL of blood. Unusually high or low lymphocyte counts can be a sign of disease.How do you get your lymphocytes normal?
Follow a healthy diet plan, get plenty of rest, and avoid germs as your body recovers its lymphocyte levels. Eat a nutrient-rich diet to feel better and more energized. Your doctor or nutritionist can help you choose whole foods that are right for you and are packed with protein and healing minerals and vitamins.Can low lymphocytes mean cancer?
Lymphocytopenia can point to a number of conditions and diseases. Some, like the flu or mild infections, aren't serious for most people. But a low lymphocyte count puts you at greater risk of infection. some cancers, including lymphocytic anemia, lymphoma, and Hodgkin disease.What level of lymphocytes is dangerous?
A count significantly higher than 3,000 lymphocytes in a microliter of blood is generally considered to be lymphocytosis in adults. In children, the threshold for lymphocytosis varies with age. It can be as high as 9,000 lymphocytes per microliter.Are lymphocytes good?
Lymphocytes are a type of white blood cell. They play an important role in your immune system, helping your body fight off infection. Many underlying medical conditions can cause lymphocytosis. High lymphocyte blood levels indicate your body is dealing with an infection or other inflammatory condition.Is 3.7 WBC count too low?
Generally, a count lower than 3,500 white blood cells per microliter of blood is considered a low white blood cell count. A white blood cell count that is just slightly below the cutoff for the established normal range may actually still be normal and not require further evaluation.How long does a lymphocyte live?
Most lymphocytes are short-lived, with an average life span of a week to a few months, but a few live for years, providing a pool of long-lived T and B cells. These cells account for immunologic “memory,” a more rapid, vigorous response to a second encounter with the same antigen.How do you identify lymphocytes?
The round, uniform nucleus and small amount of cytoplasm surrounding it are the best identifying characteristics for this cell. Lymphocytes are involved in the specific immune response including antigen-antibody reactions.What does healthy blood cells look like?
In a normal blood smear, red blood cells will appear as regular, round cells with a pale center. Variations in the size or shape of these cells may suggest a blood disorder.Which white blood cells prevent blood clots from forming to quickly?
The normal range of the number of white blood cells in a microliter of blood is between 3,700 and 10,500. Higher and lower levels of white blood cells can indicate disease. Platelets, or thrombocytes: These interact with clotting proteins to prevent or stop bleeding.How do you distinguish between monocytes and lymphocytes?
Notice the relatively regular nuclear shape of the lymphocytes versus the more complex nuclear shape of the larger monocyte. There is also a difference in the texture of the chromatin between the two cell types. The lymphocyte chromatin is denser and clumped.How do B and T cells work?
Your body can then produce the most effective weapons against the invaders, which may be bacteria, viruses or parasites. Other types of T-cells recognise and kill virus-infected cells directly. Some help B-cells to make antibodies, which circulate and bind to antigens. A T-cell (orange) killing a cancer cell (mauve).What is Lymphs absolute?
Lymphocytes, absolute (LY, abs) or. percentage (LY, pct) Measures the number or percentage of lymphocytes, which are white. blood cells that include B-cells, T-cells, and natural killer cells. 800-5,000 cells/mcL (abs)What do you mean by Lymphocytes?
Lymphocytes: A small white blood cell (leukocyte) that plays a large role in defending the body against disease. Lymphocytes are responsible for immune responses. There are two main types of lymphocytes: B cells and T cells.What are B and T lymphocytes?
T cells (thymus cells) and B cells (bone marrow- or bursa-derived cells) are the major cellular components of the adaptive immune response. T cells are involved in cell-mediated immunity, whereas B cells are primarily responsible for humoral immunity (relating to antibodies).Why are white blood cells stain purple?
The leukocytes (white blood cells) are larger than red blood cells and they have nuclei that stain dark purple. The granules are so dark that you can't see the nucleus.